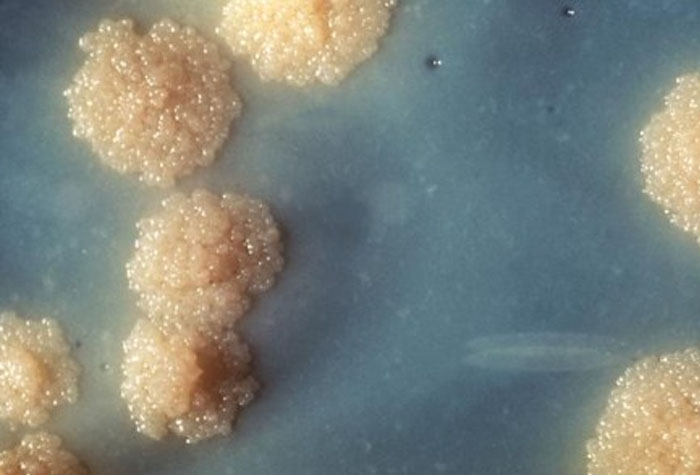

Embora a tuberculose seja conhecida há séculos e tenha cura, ainda se trata da infecção bacteriana que mais mata no mundo. O tratamento padrão exige ao menos seis meses de uso diário de ao menos quatro antibióticos e pode chegar a dois anos quando há resistência ao esquema tradicional, o que dificulta a adesão e contribui para o abandono e falhas terapêuticas.
“A doença é curável, mas o tratamento é longo e pesado. O paciente toma vários antibióticos todos os dias e isso pode causar efeitos colaterais, afetar os rins e o fígado”, explica Fernando Rogério Pavan, orientador do estudo e coordenador da área de Pesquisa de Fármacos contra a Tuberculose.
A Organização Mundial da Saúde (OMS) estima que, sem tratamento, a letalidade da tuberculose pode chegar a 50%. Por outro lado, quando o esquema é seguido corretamente, cerca de 85% dos pacientes evoluem para a cura. Mas o cenário epidemiológico brasileiro reforça a importância da busca por novos fármacos contra a doença: o Ministério da Saúde registrou 84.308 novos casos de tuberculose em 2024 e 6.025 mortes em 2023, maior número em mais de duas décadas. Os dados são os mais recentes e foram divulgados em 2025.
Mesmo com tratamento gratuito e disponível no Sistema Único de Saúde (SUS), o pesquisador explica que a adesão correta é especialmente desafiadora em populações mais vulneráveis, como pessoas em situação de rua ou com dependência de álcool. “Há doentes que interrompem o uso dos antibióticos no meio do ciclo, o que leva à resistência bacteriana. Com isso, muitos pacientes chegam a não ter mais opções terapêuticas, pois a bactéria resiste a tudo que está disponível. E essa pessoa pode transmitir essa cepa resistente para outra, criando um ciclo ainda mais perigoso”, ressalta Pavan.
O grupo liderado por Pavan estuda possíveis ações de moléculas contra a tuberculose há cerca de 20 anos. Desta vez, no doutorado da pesquisadora Fernanda Manaia Demarqui, a ideia foi investigar a substância ferroína – nome científico, conhecida como FEP –, composto muito antigo (existe desde a década de 1950) e tradicionalmente usado em sínteses químicas.
A proposta partiu do reposicionamento de fármacos, ou seja, testar substâncias já conhecidas para novos usos terapêuticos. “Nós não inventamos uma molécula nova. Pegamos uma substância antiga, barata, solúvel em água e testamos para tuberculose. Quando vimos atividade antimicrobiana, pensamos: isso pode virar uma tese”, conta o pesquisador.
Nos testes em laboratório, a FEP mostrou forte ação contra o bacilo da tuberculose, inclusive ampliando a ação da rifampicina e da pretomanida, dois medicamentos utilizados no tratamento da doença. Além disso, o grupo conseguiu descobrir o mecanismo de ação da substância.
Segundo Pavan, microscopias e sequenciamento genômico mostraram danos importantes na parede celular da bactéria, sugerindo ação semelhante a de penicilinas. “Descobrimos que ele age inibindo a síntese da parede celular. A microscopia mostra a morfologia da bactéria toda alterada e mutações em seu genoma correspondem a proteínas da parede celular”, explica Pavan.
Por ser uma substância “instável” e que poderia ser degradada ainda no estômago, os pesquisadores encapsularam o composto em nanopartículas lipídicas (NLS@FEP), que funcionam como uma “embalagem” de liberação controlada. Dessa maneira, eles conseguiram melhorar sua estabilidade e seu tempo de ação no organismo. “Essa cápsula protege a substância e permite que a liberação seja gradativa, mantendo o composto ativo por mais tempo. É uma formulação simples, feita com colesterol e fosfatidilcolina, de baixo custo e fácil produção”, diz o pesquisador.
O passo seguinte foi testar o composto em animais. Eles foram divididos em grupos de sete camundongos infectados com a Mycobacterium tuberculosis – metade foi tratada da maneira convencional e metade recebeu o composto. Após 30 dias, o grupo observou a eliminação completa da infecção pulmonar tanto com o FEP livre quanto com o encapsulado. O desempenho superou o da isoniazida, um dos antibióticos padrão do SUS.
“O resultado nos surpreendeu muito positivamente porque nós torcíamos para ver alguma redução da carga bacteriana. Mas os testes mostraram que o composto eliminou tudo. Não encontramos nenhum bacilo no pulmão. No grupo tratado com o antibiótico convencional, houve redução da carga de bacilos, como era esperado”, relata.
Apesar dos resultados animadores, ainda não é possível falar em aplicação clínica. Será necessário realizar estudos de toxicidade, farmacocinética e ensaios mais robustos, incluindo modelos de tuberculose resistente e casos de infecção crônica. Pavan ressalta, no entanto, que o fato de o composto não ter patente pode facilitar o avanço futuro para desenvolvimento industrial. “Isso pode interessar especialmente ao setor público. Se funcionar, será possível transformar a substância em medicamento sem grandes custos.”
Caso novos estudos confirmem a eficácia e a segurança em humanos, a expectativa de Pavan é que o composto abra caminho para tratamentos mais curtos, com menos efeitos adversos e maior adesão, reduzindo o risco de resistência e o impacto da doença no país. “O principal nós já sabemos: funciona. Agora precisamos ajustar dose, tempo de uso, repetir testes e avançar. Mas ver eliminação total em modelo animal nos dá esperança”, conclui.














